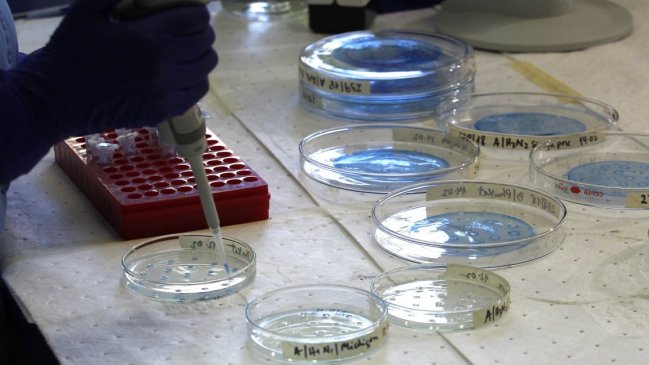
Minsal e ISP ordenan retiro de suplemento para recién nacidos por presencia de bacteria

Minsal e ISP ordenan retiro de suplemento para recién nacidos por presencia de bacteria
Se detectaron cuatro casos de pacientes afectados en dos centros asistenciales de Santiago.

Se detectaron cuatro casos de pacientes afectados en dos centros asistenciales de Santiago.

La subsecretaria de Salud Pública, Paula Daza, informó este miércoles que se ordenó el retiro de un suplemento alimenticio para recién nacidos luego de que se detectara la presencia de una bacteria en algunas de sus muestras.
La autoridad, en conjunto con la directora del Instituto de Salud Pública (ISP), Judith Mora, informó que "el 11 de febrero se acercó de la administración de (la empresa) Therapía que es de Recetario Magistral al ISP informando que dos de las tres contramuestras que hacen de este producto, que es de nutrición complementaria que se usa en pacientes que están hospitalizados en unidades de cuidados críticos y que se administra por vía endovenosa, estaban contaminadas por una bacteria".
"En forma inmediata, el ISP le exigió a la empresa que suspendiera la elaboración de este producto y comenzara la investigación. Se comunicó rápidamente a Redes Asistenciales y hasta la fecha se han notificado cuatro pacientes que los exámenes mostraron la contaminación con este producto, los que están evolucionando de forma positiva", añadió Daza.
"Sin embargo, como medida preventiva, el ISP le ha pedido a la empresa la suspensión de faenas y la suspensión de entrega de este producto a centros asistenciales", aseveró.
La subsecretaria de Salud Pública enfatizó que "este es un producto que se usa por vía endovenosa, por lo tanto puede producir una bacteremia, puede producir una infección que puede ser compleja, puede ser grave, puede producir una septicemia".
Daza recalcó que se inició "un proceso de investigación, hay un sumario sanitario y que, en base a los resultados de la investigación, aplicarán las sanciones correspondientes".
"Ningún paciente fue tratado con el suplemento"
El jefe de división de gestión de la Red Asistencial, Héctor Fuenzalida, dijo que este miércoles ningún paciente fue tratado con el suplemento.
"Ningún paciente ha recibido este tratamiento complementario en nuestras redes asistenciales, los 22 hospitales son más de 200 pacientes que habían recibido este producto magistral desde este empresa y se buscaron inmediatamente las alternativas que son nutriciones complementarias muy específicas, hechas a la medida de cada paciente", comentó el funcionario.
De acuerdo con la información entregada por las autoridades de Salud, en 22 centros médicos se distribuyó el suplemento pero solo en dos se produjeron casos reactivos a la bacteria: el Hospital de La Florida y el Hospital Félix Bulnes.